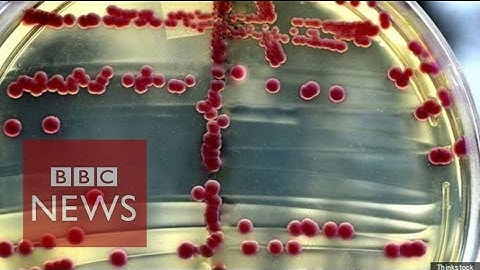
What is a superbug? BBC News
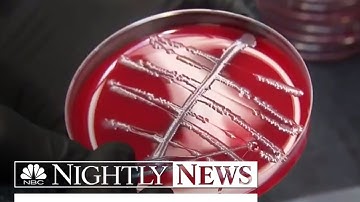
Drug-Resistant Superbugs Are ‘Fundamental Threat’ To Humans, WHO Says | NBC Nightly News

⬇ DOWNLOAD NOW
Kalau muncul iklan pop-up, tutup lalu klik tombol kembali
Download lagu Superbugs And Antibiotics: How To Prevent Superbug Bacteria | Better | NBC News secara gratis hanya untuk keperluan promosi. Dukung artis favorit kamu dengan membeli musik original di iTunes atau platform resmi lainnya.
What is a superbug? BBC News
What is a superbug? BBC News
 What causes antibiotic resistance? - Kevin Wu
What causes antibiotic resistance? - Kevin Wu
 Antibiotic Resistance and the Rise of Superbugs
Antibiotic Resistance and the Rise of Superbugs
Drug-Resistant Superbugs Are ‘Fundamental Threat’ To Humans, WHO Says | NBC Nightly News
Drug-Resistant Superbugs Are ‘Fundamental Threat’ To Humans, WHO Says | NBC Nightly News
 A new way to kill "superbugs"
A new way to kill "superbugs"
 Here's why 'superbugs' are becoming the new normal | Just The FAQs
Here's why 'superbugs' are becoming the new normal | Just The FAQs
 Stop the Superbugs
Stop the Superbugs
 Long-Feared Drug-Resistant Superbug Found for First Time in U.S. | NBC Nightly News
Long-Feared Drug-Resistant Superbug Found for First Time in U.S. | NBC Nightly News